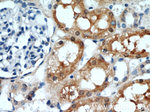
RGN/SMP30 Antibody in Immunohistochemistry (Paraffin) (IHC (P))

Search
Proteintech
RGN/SMP30 Polyclonal Antibody
{{$productOrderCtrl.translations['antibody.pdp.commerceCard.promotion.promotions']}}
{{$productOrderCtrl.translations['antibody.pdp.commerceCard.promotion.viewpromo']}}
{{$productOrderCtrl.translations['antibody.pdp.commerceCard.promotion.promocode']}}: {{promo.promoCode}} {{promo.promoTitle}} {{promo.promoDescription}}. {{$productOrderCtrl.translations['antibody.pdp.commerceCard.promotion.learnmore']}}
产品信息
17947-1-AP
种属反应
已发表种属
宿主/亚型
分类
类型
抗原
偶联物
形式
浓度
规格
纯化类型
保存液
内含物
保存条件
运输条件
产品详细信息
Immunogen sequence: MSSIKIECV LPENCRCGES PVWEEVSNSL LFVDIPAKKV CRWDSFTKQV QRVTMDAPVS SVALRQSGGY VATIGTKFCA LNWKEQSAVV LATVDNDKKN NRFNDGKVDP AGRYFAGTMA EETAPAVLER HQGALYSLFP DHHVKKYFDQ VDISNGLDWS LDHKIFYYID SLSYSVDAFD YDLQTGQISN RRSVYKLEKE EQIPDGMCID AEGKLWVACY NGGRVIRLDP VTGKRLQTVK LPVDKTTSCC FGGKNYSEMY VTCARDGMDP EGLLRQPEAG GIFKITGLGV KGIAPYSYAG (1-299 aa encoded by BC073173)
靶标信息
The protein encoded by this gene is a highly conserved, calcium-binding protein, that is preferentially expressed in the liver and kidney. It may have an important role in calcium homeostasis. Studies in rat indicate that this protein may also play a role in aging, as it shows age-associated down-regulation. This gene is part of a gene cluster on chromosome Xp11.3-Xp11.23. Alternative splicing results in two transcript variants having different 5' UTRs, but encoding the same protein.
仅用于科研。不用于诊断过程。未经明确授权不得转售。
生物信息学
蛋白别名: epididymis secretory protein Li 41; Gluconolactonase; GNL; RC; Regucalcin; Senescence marker protein 30; SMP-30; unnamed protein product
基因别名: AI265316; GNL; HEL-S-41; RC; Reguc; RGN; SMP30
UniProt ID: (Human) Q15493, (Rat) Q03336, (Mouse) Q64374
Entrez Gene ID: (Human) 9104, (Rat) 25106, (Mouse) 19733